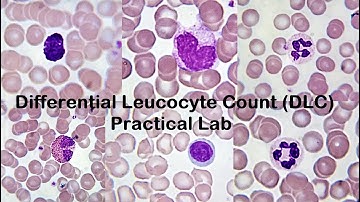
Differential Leucocyte Count DLC Practical Lab

⬇ DOWNLOAD NOW
Kalau muncul iklan pop-up, tutup lalu klik tombol kembali
Download lagu Total Leukocyte Count | TLC Blood Test Procedure | Total WBC Count Experiment secara gratis hanya untuk keperluan promosi. Dukung artis favorit kamu dengan membeli musik original di iTunes atau platform resmi lainnya.
 Total WBC count Practical Lab
Total WBC count Practical Lab
 Determination of WBC count (TLC -Total leucocyte count) | MUHS | #mbbs #practical #hematology
Determination of WBC count (TLC -Total leucocyte count) | MUHS | #mbbs #practical #hematology
 Total Leucocyte Count
Total Leucocyte Count
 4 White Cell Count: Microscope Check
4 White Cell Count: Microscope Check
Differential Leucocyte Count DLC Practical Lab
Differential Leucocyte Count DLC Practical Lab
 Total RBC Count Practical Lab
Total RBC Count Practical Lab
 #tlctest #TLCBloodTest Total Leukocyte Count | TLC | Total WBC Count Experiment #medlab #MedLab
#tlctest #TLCBloodTest Total Leukocyte Count | TLC | Total WBC Count Experiment #medlab #MedLab
 Total Leukocyte Count (total WBC count) by using Hemocytometer, Hindi version
Total Leukocyte Count (total WBC count) by using Hemocytometer, Hindi version